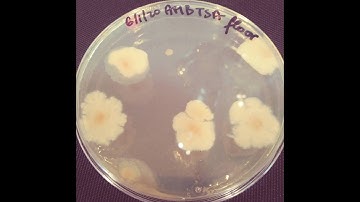
Environmental Sample for Microlab-At-Home

⬇ DOWNLOAD NOW
Kalau muncul iklan pop-up, tutup lalu klik tombol kembali
Download lagu Microbiological environmental surface sampling using an agar contact plate secara gratis hanya untuk keperluan promosi. Dukung artis favorit kamu dengan membeli musik original di iTunes atau platform resmi lainnya.
 Environmental Surface Sampling Using Contact Agar Plates
Environmental Surface Sampling Using Contact Agar Plates
 Environmental Surface Sampling with Agar Plates
Environmental Surface Sampling with Agar Plates
 SAMPLING | Contact Plate Sampling: How to Sample Surfaces Using Contact Plates
SAMPLING | Contact Plate Sampling: How to Sample Surfaces Using Contact Plates
 SAMPLING | Environmental Sponge & Swab Sampling Training
SAMPLING | Environmental Sponge & Swab Sampling Training
 Sampling with Rodac Plates
Sampling with Rodac Plates
 Environmental sampling: surfaces
Environmental sampling: surfaces
Environmental Sample for Microlab-At-Home
Environmental Sample for Microlab-At-Home
 Gloved Fingertip Sampling Using Agar Plates
Gloved Fingertip Sampling Using Agar Plates